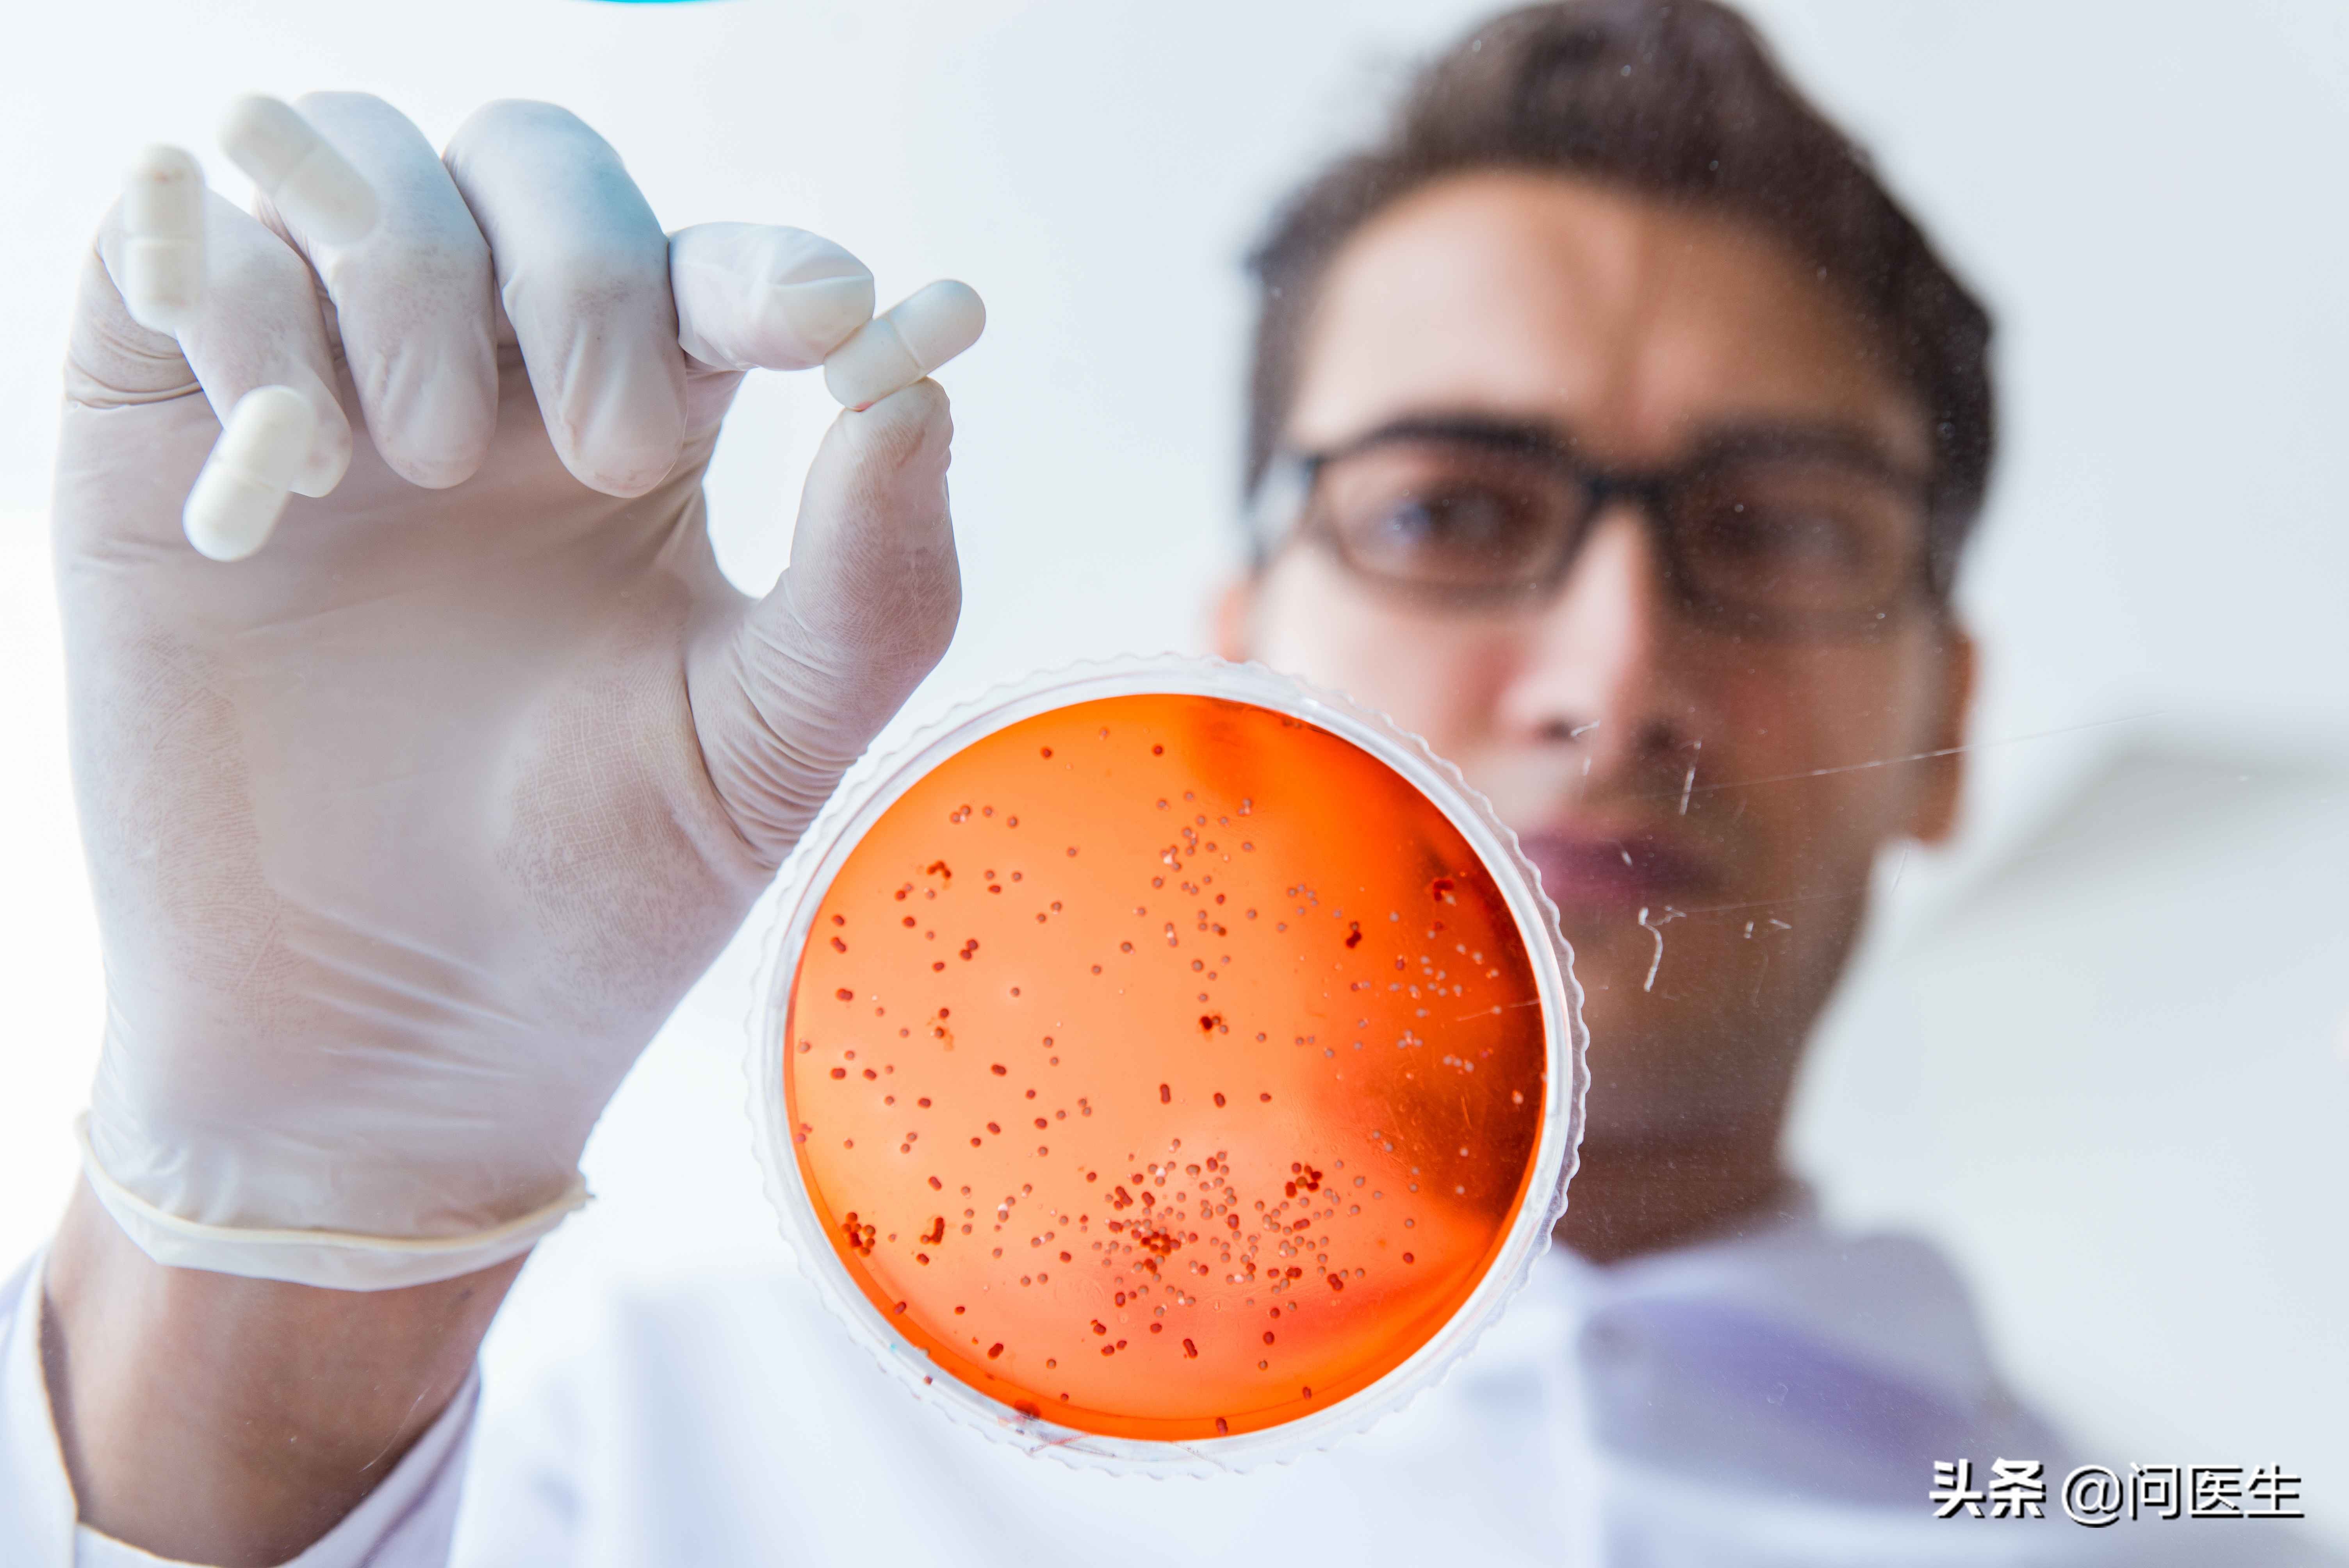
肛门瘙痒是肠癌症状吗,肠癌肛门会瘙痒吗

肛门瘙痒真的会痒得很难受,也会痒得寝食难安。瘙痒难耐,很想去挠,走在路上有时都会想挠一把,真是好尴尬。由于肛门瘙痒的位置比较特殊,很多人也都是遮遮掩掩的不愿意启齿,这在医学上是很常见的一个现象,一般常见于一些皮肤病或者其他的疾病。
肛门瘙痒一般常见于年轻人,老年人也会出现,如果出现了肛门瘙痒的情况,建议及时要去医院查明原因,不然会蔓延到阴囊或者阴唇,就会加重病情。

为什么会出现肛门瘙痒?
肛门瘙痒其实不是一个单一的疾病,是很多疾病的一个症状,在生活中也非常的常见。
这种瘙痒可以发生在肛门周围,也可以发生在肛门里面,经过抓挠后发现有所缓解,但是好景不长,过不了多久又出现了奇痒难忍,甚至越抓越痒,严重还会导致肛门周围的皮肤出血、红肿疼痛等,症状会越来越严重,甚至一发不可收拾。

肛门瘙痒难耐怎么回事?或者这几大原因
1.肛门周围皮肤病
如果肛门周围的皮肤出现了问题,比如神经性的皮炎、癣、湿疹。甚至性病等,都会引起肛门瘙痒。再加上肛门褶皱的皮肤内容易出现粪便等等,刺激肛门会更容易引起瘙痒。
2.肛门直肠的疾病
比如痔疮、肛瘘、结直肠癌等均可引起肛门的瘙痒。这些疾病还会无意中导致大便外溢,污染肛门周围的皮肤,这样就会出现肛门周围皮肤出现破损,引起疼痛,皮下出现肛瘘的窦道也会经久不愈。

3.内分泌疾病
如果皮肤中的含糖量升高的话,就会刺激神经末梢,也会引起不同程度的瘙痒,其次甲亢也会可能引起皮肤的瘙痒,这一般与出汗多、基础代谢率升高和情绪紧张都有关系。
4.寄生虫病
比如蛲虫、蛔虫、阴道毛滴虫、阴虱等等,都会造成肛门瘙痒的症状出现。
5.过敏
很多人属于过敏体质,吃了刺激性的食物就会出现肛门瘙痒或者肛门刺痛的感觉。还有一些人对一些药物过敏的话,也会引起肛门的瘙痒,比如治疗痛风、关节炎的一些药物,或者治疗肛周疾病的乳膏也会引起过敏的现象,出现肛门瘙痒的感觉。
6.精神因素或者环境因素
如果精神状态不好的时候,比如精神紧张,或者神经衰弱引起神经功能紊乱,也会诱发皮肤瘙痒的出现。或者是使用了不干净的卫生纸,穿了不干净的*裤内**,或者因为天气炎热出现了肛门周围潮湿的情况,都会造成瘙痒。

出现肛门瘙痒,不要做这3件事!
1.不要乱用止痒药膏
很多人出现肛门瘙痒后,不好意思看医生,就去自己买一些止痒的药膏来涂抹,可能短时间内会有效果,但是治标不治本,后期可能容易复发,也有可能会掩盖病情,造成病情复杂。

2.不要用肥皂水清洗
出现肛门瘙痒注意不要用肥皂水清洗,过度的清洁会破坏肛门的皮肤,碱性的肥皂还会刺激肛周的皮肤出现瘙痒。可以用温水冲洗就行,清洗完后用纸巾擦干就可以,注意也不要用太烫的水反复的清洗。
3.不要用手抓挠
如果用手抓挠会导致肛门周围的皮肤出现粗糙并且还会增厚,就会形成肛门皲裂,引起感染,而且手上也会带有细菌,蔓延到会阴部位又会引起感染。所以有肛门瘙痒的情况,一定不要用手抓,如果实在是瘙痒难耐,可以用棉签轻轻地擦拭。

偶尔的出现一次肛门瘙痒,不必担心,可能是由于肛门局部不洁造成的,注意平时清洁好卫生即可。
但如果经常发生肛门瘙痒还很难以控制的恶化,反复发作或者大便习惯也发生了改变,就需要到医院肛肠科进行检查明确原因,对症治疗。出现肛门瘙痒的症状需要引起重视,但也不必谈癌色变。